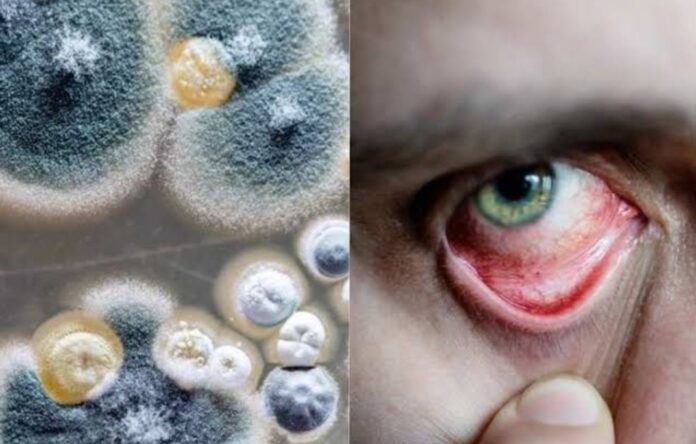

नई दिल्ली: तूफान ताउते के बाद अब एक और चक्रवाती तूफान यास का खतरा पश्चिम बंगाल और ओडिशा में बन गया है। चक्रवाती तूफान का प्रभाव बंगाल और ओडिशा में दिखने लगा है। राज्यों में तेज हवाएं और बारिश शुरू हो गई है। वहीं एनडीआरएफ की कई टीमें अलर्ट मोड पर है। चक्रवाती तूफान में बदलने के बाद यास उत्तर पश्चिम की ओर बढऩे लगा है। मौसम विभाग ने पहले ही बताया था कि ओडिशा और पश्चिम बंगाल में आज से असर दिखने लगेगा। कई इलाकों में तेज हवाओं के साथ बारिश शुरु हो गई है।
चक्रवात यास को लेकर गृहमंत्री अमित शाह ने हाल ही में उड़ीसा, बंगाल, आंध्र के सीएम और अंडमान के साथ बैठक की थी और अस्पताल को पावर बैकअप सुनिश्चित करने के निर्देश दिए थे। भारत मौसम विज्ञान विभाग के अनुसार, पूर्व मध्य बंगाल की खाड़ी के ऊपर कल का विक्षोभ पश्चिम उत्तर पश्चिम दिशा में बढ़ा और मध्य रात्रि में इसी क्षेत्र में एक गहरे विक्षोभ में बदल हो गया। इसके बाद, यह धीरे धीरे उत्तर-उत्तर-पश्चिम दिशा में बढ़ा और आज, 24 मई, 2021 को सुबह में पूर्व मध्य बंगाल की खाड़ी के ऊपर चक्रवाती तूफान ‘यास’ के रूप में तेज हो गया।
आज भारतीय मानक समय 08.30 बजे, यह पोर्ट ब्लेयर (अंडमान द्वीपसमूह) से लगभग 620 किमी उत्तर उत्तर पश्चिम, पारादीप (ओडिशा) के 530 किमी दक्षिण दक्षिण पूर्व, बालासोर (ओडिशा) के 630 किमी दक्षिण दक्षिण पूर्व और दीघा (पश्चिम बंगाल) के 620 किमी दक्षिण दक्षिण पूर्व के निकट अक्षांश 16.4 डिग्री उत्तर और देशांतर 89.6 डिग्री पूर्व में केंद्रित रहा।
इसके अगले 12 घंटों में उत्तर-उत्तर-पश्चिम दिशा में बढऩे, एक उग्र चक्रवाती तूफान में तेज होने और उसके बाद के 24 घंटों में एक बेहद उग्र चक्रवाती तूफान में बदल जाने का अनुमान है। यह उत्तर-उत्तर-पश्चिम दिशा में बढऩा जारी रखेगा, और सघन होगा और 26 मई की सुबह में उत्तर ओडिशा और पश्चिम बंगाल के निकट उत्तर पश्चिम बंगाल की खाड़ी में इसके पहुंचने का अनुमान है। एक बेहद उग्र चक्रवाती तूफान के रूप में 26 मई की दोपहर में इसके पारादीप और सागर द्वीपसमूहों के बीच उत्तर ओडिशा-पश्चिम बंगाल तटों को पार करने का अनुमान है।
उत्तरी तटीय आंध्र प्रदेश : 24 मई को कई स्थानों पर हल्की से मध्यम वर्षा और अलग अलग स्थानों पर भारी वर्षा और 25 मई को अलग अलग स्थानों पर भारी से बहुत भारी वर्षा का अनुमान है।
24 मई को तटीय ओडिशा के ऊपर कई स्थानों पर हल्की से मध्यम वर्षा और अलग अलग स्थानों पर भारी वर्षा, 25 मई को पुरी, जगतसिंहपुर, खुरदा, कटक, केंद्रपारा, जाजपुर, भद्रक, बालासोर, गंजाम, धेनकनल, मयूरभंज जिलों में भारी वर्षा, होने का अनुमान है।
26 मई को जगतसिंहपुर, कटक, केंद्रपारा, जाजपुर, भद्रक, बालासोर, मयूरभंज, कियोंझारगढ़, पुरी, खुरदा, अंगुल, देवगढ़, सुंदरगढ़ में अलग अलग स्थानों पर भारी वर्षा हो सकती है। वहीं 27 मई को उत्तरी आंतरिक ओडिशा में अलग अलग स्थानों पर भारी वर्षा होने का अनुमान है।
मछुआरों को 24-25 मई के दौरान मध्य बंगाल की खाड़ी और 24-26 मई के दौरान उत्तर बंगाल की खाड़ी और उत्तरी आंध्र प्रदेश-ओडिशा-पश्चिम बंगाल-बांग्ला देश तटों के करीब न जाने का सुझाव दिया गया है। जो लोग उत्तर के गहरे समुद्र और समीपवर्ती मध्य बंगाल की खाड़ी में गए हुए हैं, उन्हें तट पर लौट आने का सुझाव दिया गया है।
खगोलीय ज्वार से ऊपर 2-4 मीटर की ज्वारीय लहरों के जमीन से टकराने के दौरान झारग्राम, दक्षिण 24 परगना, मेदिनीपुर, बालासोर भद्रक, कंद्रपारा और जगतसिंहपुर जिलों के निचले तटीय क्षेत्रों के जलमग्न होने की आशंका है। प्रणाली के सघनीकरण और संभावित मूवमेंट की लगातार निगरानी की जा रही है और संबंधित राज्य सरकारों को नियमित रूप से सूचित किया जा रहा है।
भारतीय मौसम विभाग ने सोमवार को कहा कि चक्रवाती तूफान यास के तीन पूर्वोत्तर राज्यों – असम, मेघालय और सिक्किम को प्रभावित करने की संभावना है, जिसके चलते 26-27 मई को मध्यम से भारी बारिश हो सकती है। विभाग के अधिकारियों ने कहा कि बारिश की तीव्रता चक्रवात की चाल पर निर्भर करेगी।
वहीं असम के मुख्यमंत्री हिमंत बिस्वा सरमा ने एक ट्वीट में कहा, चक्रवात यास के 26-27 मई को (पूर्वोत्तर) क्षेत्र को प्रभावित करने की संभावना है। माननीय गृहमंत्री अमित शाह ने फोन कर असम, सिक्किम और मेघालय की तैयारियों के बारे में जानकारी ली है।
मुख्यमंत्री ने कहा, उन्हें सूचित किया गया है कि आपातकालीन सेवाओं पर काम जारी है। यहां के प्रति उनकी निरंतर चिंता को देखते हुए गृहमंत्री का आभारी हूं। त्रिपुरा में आईएमडी के निदेशक दिलीप साहा ने कहा कि पूर्वोत्तर क्षेत्र के कई राज्यों में हल्की से मध्यम बारिश होने की संभावना है। साहा ने बताया, क्षेत्र में कुछ स्थानों पर भारी बारिश भी हो सकती है। हालांकि, बारिश और हवा की गति तूफान की ताकत और दिशा पर निर्भर करेगी।